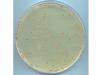
Итоги эксперимента по искусственной эволюции, который длился 21 год, озадачили биологов

Комментарии участников:
озадаченность у журналистов Ленты, они не смогли перевести с "английского" Escherichia coli и понять, чем цитрат отличается от цитруса.
В районе поколения с номером 26 тысяч скорость накопления мутаций заметно возросла. Анализ показал, что практически все из этих "поздних" мутаций не давали бактериям преимущества по сравнению с конкурентами.
Вот в чем озадаченность… До поколений в районе 26 тысяч мутации бактерий давали примущества, а "поздние" мутации такого эффекта не дают.
Поскольку случайные мутации все же нейтральны, то речь видимо идет о прижившихся в новых поколениях мутациях. А значит поколение 26000-е сильно отличалось от первого.
И рассчитывать на то, что одни условия будут влиять одинаково на разные поколения с разными степенями мутаций, было довольно опрометчиво.
Видимо для поколений после 26000, в результате предыдущих мутаций, важнее оказалось что-то другое
И рассчитывать на то, что одни условия будут влиять одинаково на разные поколения с разными степенями мутаций, было довольно опрометчиво.
Видимо для поколений после 26000, в результате предыдущих мутаций, важнее оказалось что-то другое
Достаточно было постоянно уменьшать глюкозу и увеличивать цитрат, накладывая не стационарные, а меленно(примерно со скоростью мутаций) меняющиеся граничные условия, т.е. наращивать преимущества мутировавших. Как говаривола моя бабушка, если у человека ума нет, то своего не дашь. Сия сентенция и легла в основу недоУМЕНИЯ. Пусть простят меня групповые мечиганские биологи за снобизм.
Опять же зачем им это делать. Эксперимент и так показал, что в постоянных условиях мутация шла с постоянной скоростью и в ущерб адаптации, а потом скорость мутаций неожиданно возросла уже без необходимости адаптации вообще. Видимо озадаченность как раз в этом новом факте неоднозначной корреляции мутации и адаптации.
Накопление "ПАРАЗИТНЫХ" мутаций (выше предела) может вызвать скачкообразное ослабление популяци, что в свою очередь вынужденно приведет к увеличению мутаций в тех же благоприятных условиях. Условия те же, да популяция захирела. Да и можно ли говорить об адаптации к цитрату, если глюкозы был и так избыток?
Вы явно искажаете смысл термина "эволюция". Задача была не создать жёсткие условия и наблюдать вынужденное приспособление. А получить эффект естественной эволюции, т.е. развитие в постоянных условиях. Наших предков никто с дерева не гнал, т.е. ваши предложения фактически имеют религиозный подтекст про участие сторонних сил в эволюционных процессах.
Ну про религиозный подтекст Вы пожалуй загнули. Я придеживаюсь как раз другого мнения, что все Религии и Веры плод человеческой фантазии и следствие приспособления различных популяций к условиям внешней среды.
Что касается "СТАЦИОНАРНЫХ" внешних условий в эволюции Земли то тут всё очевидно. Так что если говорить о ЕСТЕСТВЕННОЙ эволюции, то она происходила в изменяющихся (иногда быстро, иногда медленно) условиях, как то температура, освещенность, влажность, газовый состав, естественная радиация и пр., пр., пр. В качестве локальной модельной задачи — накопления неблагоприятных признаков — стационарные условия тоже полезны. Видимо динозавры за эти стационарные условия и пострадали.
Что касается "СТАЦИОНАРНЫХ" внешних условий в эволюции Земли то тут всё очевидно. Так что если говорить о ЕСТЕСТВЕННОЙ эволюции, то она происходила в изменяющихся (иногда быстро, иногда медленно) условиях, как то температура, освещенность, влажность, газовый состав, естественная радиация и пр., пр., пр. В качестве локальной модельной задачи — накопления неблагоприятных признаков — стационарные условия тоже полезны. Видимо динозавры за эти стационарные условия и пострадали.
Видимо биологи озадачились тем фактом, что бездарно потратили на глистов 21 год жизни и кучу денег налогоплатильщиков. Но так как признаться в этом не дали стыд и мафиознонаучный этикет, поэтому сказали что адаптационные воздействия и мутации связаны сложнее чем им думалось.